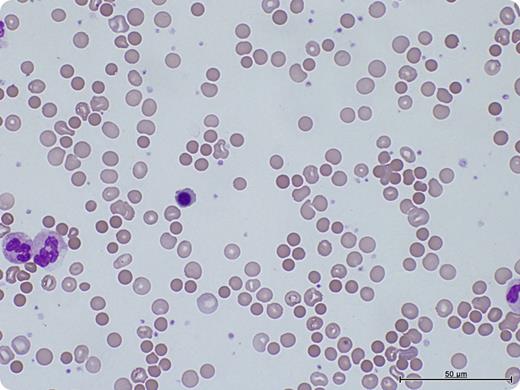
A 64-year-old male underwent a bilateral sequential lung transplant for chronic obstructive pulmonary disease. The donor blood group was O-positive; recipient was A-positive. His hemoglobin fell from 134g/L preoperatively to 93g/L postoperatively and continued to fall to 79g/L 10 days after transplantation. There was no obvious bleeding source. Despite transfusion of 2 units of resuspended red blood cells, there was no improvement. Hemolytic markers were suggestive of hemolysis (raised lactate dehydrogenase, raised bilirubin, and reduced haptoglobin). Blood film showed marked spherocytosis, polychromasia, and nucleated red blood cells (see figure). Direct antiglobulin test was positive, with an elution revealing anti-A1 antibodies. The immune-mediated hemolysis resolved with observation and support with O-positive red blood cells. / Passenger lymphocyte syndrome is an important cause of anemia after solid organ and stem cell transplant occurring 3 to 15 days after transplantation. It is caused by lymphocytes within the donor organ producing antibodies against the recipient's red blood cells. Patients with lung and heart transplants are at high risk for passenger lymphocyte syndrome. It is usually a self-limiting condition, although severe cases have been treated with immunosuppression, plasma exchange, and red cell exchange. Because of the variability in severity and duration, close monitoring until resolution is recommended.

A 64-year-old male underwent a bilateral sequential lung transplant for chronic obstructive pulmonary disease. The donor blood group was O-positive; recipient was A-positive. His hemoglobin fell from 134g/L preoperatively to 93g/L postoperatively and continued to fall to 79g/L 10 days after transplantation. There was no obvious bleeding source. Despite transfusion of 2 units of resuspended red blood cells, there was no improvement. Hemolytic markers were suggestive of hemolysis (raised lactate dehydrogenase, raised bilirubin, and reduced haptoglobin). Blood film showed marked spherocytosis, polychromasia, and nucleated red blood cells (see figure). Direct antiglobulin test was positive, with an elution revealing anti-A1 antibodies. The immune-mediated hemolysis resolved with observation and support with O-positive red blood cells.
Passenger lymphocyte syndrome is an important cause of anemia after solid organ and stem cell transplant occurring 3 to 15 days after transplantation. It is caused by lymphocytes within the donor organ producing antibodies against the recipient's red blood cells. Patients with lung and heart transplants are at high risk for passenger lymphocyte syndrome. It is usually a self-limiting condition, although severe cases have been treated with immunosuppression, plasma exchange, and red cell exchange. Because of the variability in severity and duration, close monitoring until resolution is recommended.
A 64-year-old male underwent a bilateral sequential lung transplant for chronic obstructive pulmonary disease. The donor blood group was O-positive; recipient was A-positive. His hemoglobin fell from 134g/L preoperatively to 93g/L postoperatively and continued to fall to 79g/L 10 days after transplantation. There was no obvious bleeding source. Despite transfusion of 2 units of resuspended red blood cells, there was no improvement. Hemolytic markers were suggestive of hemolysis (raised lactate dehydrogenase, raised bilirubin, and reduced haptoglobin). Blood film showed marked spherocytosis, polychromasia, and nucleated red blood cells (see figure). Direct antiglobulin test was positive, with an elution revealing anti-A1 antibodies. The immune-mediated hemolysis resolved with observation and support with O-positive red blood cells.
Passenger lymphocyte syndrome is an important cause of anemia after solid organ and stem cell transplant occurring 3 to 15 days after transplantation. It is caused by lymphocytes within the donor organ producing antibodies against the recipient's red blood cells. Patients with lung and heart transplants are at high risk for passenger lymphocyte syndrome. It is usually a self-limiting condition, although severe cases have been treated with immunosuppression, plasma exchange, and red cell exchange. Because of the variability in severity and duration, close monitoring until resolution is recommended.
For additional images, visit the ASH IMAGE BANK, a reference and teaching tool that is continually updated with new atlas and case study images. For more information visit http://imagebank.hematology.org.